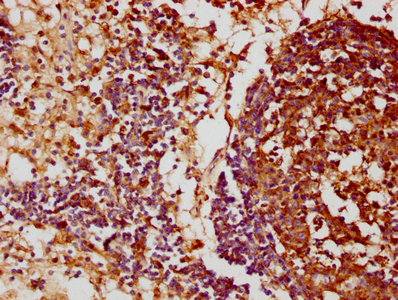

FCRL3 Antibody
-
中文名稱:FCRL3兔多克隆抗體
-
貨號(hào):CSB-PA853475LA01HU
-
規(guī)格:¥440
-
圖片:
-
IHC image of CSB-PA853475LA01HU diluted at 1:100 and staining in paraffin-embedded human lymph node tissue performed on a Leica BondTM system. After dewaxing and hydration, antigen retrieval was mediated by high pressure in a citrate buffer (pH 6.0). Section was blocked with 10% normal goat serum 30min at RT. Then primary antibody (1% BSA) was incubated at 4°C overnight. The primary is detected by a biotinylated secondary antibody and visualized using an HRP conjugated SP system.
-
Immunofluorescence staining of Hela cells with CSB-PA853475LA01HU at 1:33, counter-stained with DAPI. The cells were fixed in 4% formaldehyde, permeabilized using 0.2% Triton X-100 and blocked in 10% normal Goat Serum. The cells were then incubated with the antibody overnight at 4°C. The secondary antibody was Alexa Fluor 488-congugated AffiniPure Goat Anti-Rabbit IgG(H+L).
-
-
其他:
產(chǎn)品詳情
-
產(chǎn)品名稱:Rabbit anti-Homo sapiens (Human) FCRL3 Polyclonal antibody
-
Uniprot No.:
-
基因名:FCRL3
-
別名:CD307c antibody; Fc receptor homolog 3 antibody; Fc receptor-like protein 3 antibody; FcR-like protein 3 antibody; FcRH3 antibody; FcRL3 antibody; FCRL3_HUMAN antibody; hIFGP3 antibody; IFGP family protein 3 antibody; IFGP3 antibody; Immune receptor translocation-associated protein 3 antibody; Immunoglobulin superfamily receptor translocation associated protein 3 antibody; IRTA3 antibody; SH2 domain-containing phosphatase anchor protein 2 antibody; SPAP2 antibody
-
宿主:Rabbit
-
反應(yīng)種屬:Human
-
免疫原:Recombinant Human Fc receptor-like protein 3 protein (122-222AA)
-
免疫原種屬:Homo sapiens (Human)
-
標(biāo)記方式:Non-conjugated
本頁(yè)面中的產(chǎn)品,F(xiàn)CRL3 Antibody (CSB-PA853475LA01HU),的標(biāo)記方式是Non-conjugated。對(duì)于FCRL3 Antibody,我們還提供其他標(biāo)記。見(jiàn)下表:
-
克隆類型:Polyclonal
-
抗體亞型:IgG
-
純化方式:>95%, Protein G purified
-
濃度:It differs from different batches. Please contact us to confirm it.
-
保存緩沖液:Preservative: 0.03% Proclin 300
Constituents: 50% Glycerol, 0.01M PBS, pH 7.4 -
產(chǎn)品提供形式:Liquid
-
應(yīng)用范圍:ELISA, IHC, IF
-
推薦稀釋比:
Application Recommended Dilution IHC 1:20-1:200 IF 1:20-1:200 -
Protocols:
-
儲(chǔ)存條件:Upon receipt, store at -20°C or -80°C. Avoid repeated freeze.
-
貨期:Basically, we can dispatch the products out in 1-3 working days after receiving your orders. Delivery time maybe differs from different purchasing way or location, please kindly consult your local distributors for specific delivery time.
-
用途:For Research Use Only. Not for use in diagnostic or therapeutic procedures.
相關(guān)產(chǎn)品
靶點(diǎn)詳情
-
功能:Promotes TLR9-induced B-cell proliferation, activation and survival but inhibits antibody production and suppresses plasma cell differentiation. Enhances activation of NF-kappa-B and MAPK signaling pathways in TLR9 stimulated B-cells. Has inhibitory potentional on B-cell receptor (BCR)-mediated signaling, possibly through association with SH2 domain-containing phosphatases. Inhibits cell tyrosine phosphorylation, calcium mobilization and activation-induced cell death induced through BCR signaling. Regulatory T-cells expressing FCRL3 exhibit a memory phenotype, are relatively nonresponsive to antigenic stimulation in presence of IL2 and have reduced capacity to suppress the proliferation of effector T-cells.
-
基因功能參考文獻(xiàn):
- no association between the FCRL-3 rs7528684 SNP with susceptibility to allergic asthma in Iranian North-Western Azeri population. PMID: 28792713
- -169CC genotype associated with a beneficial functional effect on residual insulin secretion and HbA1c level dynamics in type 1 diabetes PMID: 27615679
- Pooled genome wide association study identified a genetic variant upstream of FCRL3 as a susceptibility locus for Graves' disease in addition to those identified in the Major Histo-compatibility Complex. PMID: 27863461
- The expression of Sezary signature genes: FCRL3, Tox, and miR-214, was significantly higher in samples from Sezary syndrome patients with CD164 expressing CD4(+) T cells. PMID: 27766406
- This study aims to investigate the association between common polymorphisms of FCRL3 gene and multiple sclerosis risk in a Chinese Han population. PMID: 25862376
- Observed no association between the MHC2TA or FCRL3 SNPs and rheumatoid arthritis in Mexican patients. PMID: 26350270
- genetic polymorphism is associated with rheumatoid arthritis in Chinese Han population PMID: 26746625
- Genetic polymorphisms in FCRL3 are genetic risk factors for neuromyelitis optica in the Chinese population. PMID: 25575677
- FCRL3_3, FCRL3_5 and FCRL3_6 polymorphisms could increase susceptibility to Graves' disease only in Asians, rather than in Caucasians. PMID: 26321232
- CTLA4 and FCRL3 genes overexpression may play an important role in children suffering from autoimmune thyroiditis. PMID: 26994388
- FCRL3 genetic polymorphisms were associated with an increased risk of endometriosis-related infertility, regardless of symptoms. PMID: 26334889
- 4 Single Nucleotide Polymorphisms (rs7528684, rs945635, rs3761959, and rs2282284) could significantly elevate the risk of Neuromyelitis Optica in Chinese Han population. PMID: 26402798
- study found a significant association between the SNPs in FCRL3 gene and allergic rhinitis (AR) in Chinese Han patients; results suggest these gene polymorphisms might be the autoimmunity risk for AR PMID: 25594855
- Association between FCRL3 polymorphisms and increased risk of sudden sensorineural hearing loss in a Chinese Han population. PMID: 26051414
- the TIGIT/FCRL3 combination allows reliable identification of Helios(+) Treg cells even in highly activated conditions in vitro as well as in PBMCs of autoimmune patients. PMID: 25762785
- CONCLUSIONS: Our study demonstrated that the FCRL3 -169T>C polymorphism is not a risk factor of systemic lupus erythematosus in the Polish population, but this polymorphism may contribute to autoantibody production in this disease. PMID: 24593204
- the FCRL3 polymorphisms are associated with not only autoimmune diseases including RA, GD, T1D, and other disease under different genetic models, but also different ethnic subgroups. PMID: 24117236
- meta-analysis of published studies including 2,544 patients and 3,913 controls demonstrates that the FCRL3 -169 C/T polymorphism does not confer susceptibility to systemic lupus erythematosus in Europeans or Asians PMID: 23512175
- FCRL3 -169T>C polymorphism alters the expression of FCRL3 and can be a risk factor of endometriosis-related infertility. PMID: 23553198
- This meta-analysis demonstrates that the FCRL3 -169 C/T polymorphism may confer susceptibility to seropositive RA in Asians.[meta-analysis] PMID: 23777926
- The results of this study showed a significant association between FCRL3-110 A/G polymorphism and susceptibility to rheumatoid arthritis. PMID: 23883198
- FCRL3 amplified the NF-kappaB and mitogen-activated protein kinase signaling cascades, and halted CpG triggered BLIMP1 induction in an ERK-dependent fashion. PMID: 23857366
- FCRL3 gene polymorphism shows positive relatationship in the development of rheumatoid arthritis. PMID: 23463945
- FCRL3 gene and its proxy SNP rs7528684 may be involved in the pathogenesis of GD by excessive inhibiting B cell receptor signaling and the impairment of suppressing function of Tregs. PMID: 23505439
- CD40 and FCRL3 gene polymorphisms were associated with autoimmune hyperthyroidism intractability. PMID: 22706687
- A male-gender juvenile rheumatoid arthritis and asthma, but not childhood-onset systemic lupus erythematosus are associated with FCRL3 polymorphisms in Mexicans. PMID: 23070121
- Polymorphisms of the FCRL3 gene may contribute to the progression of joint destruction rather than susceptibility to rheumatoid arthritis. PMID: 22386693
- A functional variant in FCRL3 is associated with higher Fc receptor-like 3 expression on T cell subsets and rheumatoid arthritis disease activity. PMID: 22392608
- Findings support a possible gene-gene interaction for FOXP3/FCRL3 polymorphisms, leading to a cumulative effect on endometriosis development. PMID: 22341374
- Frequencies of specific FcRL3 haplotypes are significantly associated with a Chinese cohort of Guillain-Barre syndrome patients compared with healthy controls. PMID: 22458979
- FCRL3 -169C/C genotype is associated with anti-citrullinated protein antibody-positive rheumatoid arthritis and with radiographic progression. PMID: 21885492
- genetic polymorphism is associated with endometriosis in Brazilian population PMID: 21663782
- the FCRL3 C-169T polymorphism may play an important role in the pathogenesis of endometriosis and/or infertility. PMID: 21529967
- The functional FCRL3 SNP -169T/C appears to play important roles in the development of certain phenotypes such as systemic lupus erythematosus leukopenia and rheumatoid arthritis disease severity in Taiwanese patients with these diseases. PMID: 21078711
- A significant association of fcrl3_3 with primary biliary cirrhosis only in Japanese. PMID: 21299530
- These results suggest that FCRL3 polymorphisms and haplotypes may contribute to genetic susceptibility to rheumatoid arthritis in a Chinese population. PMID: 20732364
- PTPN22 rs3789604 and FCRL3 rs7528684 polymorphisms are protective against Graves' disease. PMID: 19438904
- Meta-analysis suggests that the FCRL3 -169 C/T polymorphism is a significant risk factor for rheumatoid arthritis in Asians, but not in Europeans. PMID: 19690864
- FcRL3 expression is associated with T(reg) dysfunction PMID: 20190142
- The polymorphisms of the promoter A/G,exon 2 C/G,exon 4 C/T in the FcRL3 gene were risk factors to Graves disease in Chongqing Han population. PMID: 19953494
- The FCRL3 gene does not appear associated with susceptibility to HLA-B27-positive ankylosing spondylitis in Han Chinese population. PMID: 19657722
- This meta-analysis demonstrates that the FCRL3 169CC genotype (recessive effect) may confer susceptibility to systemic lupus erythematosus, especially in Asian-derived population. PMID: 19565352
- molecular cloning and characterization of SPAP2 PMID: 12051764
- Single nucleotide polymorphism in Graves' disease in a large UK Caucasian Graves' disease data set. PMID: 16384851
- This gene will not have a substantial effect in determining susceptibility to RArheumatoid arthritis in populations of Northern European descent. PMID: 16859508
- Susceptibility to type 1 autoimmune hepatitis in Japanese patients is not influenced by FcgammaRIIA, FcgammaRIIB, or FCRL3 polymorphisms. PMID: 17020818
- Findings from a large case-control sample of patients with alopecia areata (AA) do not support an association between FCRL3 and susceptibility to AA. PMID: 17117947
- Both the FCRL3 and PTPN22 genes play roles in rheumatoid arthritis susceptibility, but in different individuals. PMID: 17133579
- The association of the -169C/T SNP in FCRL3 with rheumatoid arthritis and systemic lupus erythematosus that was observed in Japanese patients was not replicated in a Korean population. PMID: 17133581
- Susceptibility to autoimmunity at the FCRL3 locus. PMID: 17200162
顯示更多
收起更多
-
相關(guān)疾病:Rheumatoid arthritis (RA)
-
亞細(xì)胞定位:Cell membrane; Single-pass type I membrane protein.
-
組織特異性:Primarily expressed in secondary lymphoid tissues by mature subsets of B-cells. Low expression on transitional B cells which increases to higher surface expression on mature and memory B-cells with innate-like features (at protein level). Expressed a low
-
數(shù)據(jù)庫(kù)鏈接:
Most popular with customers
-
-
YWHAB Recombinant Monoclonal Antibody
Applications: ELISA, WB, IHC, IF, FC
Species Reactivity: Human, Mouse, Rat
-
Phospho-YAP1 (S127) Recombinant Monoclonal Antibody
Applications: ELISA, WB, IHC
Species Reactivity: Human
-
-
-
-
-